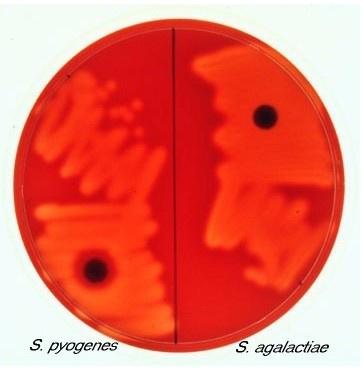
Terah Smith

Activity
Mon
Wed
Fri
Sun
Apr
May
Jun
Jul
Aug
Sep
Oct
Nov
Dec
Jan
Feb
Mar
What is this?
Less
More
Memberships
Microscope Views (FREE)
1.7k members • Free
0 contributions to Microscope Views (FREE)
Terah Smith hasn't contributed to Microscope Views (FREE) yet.